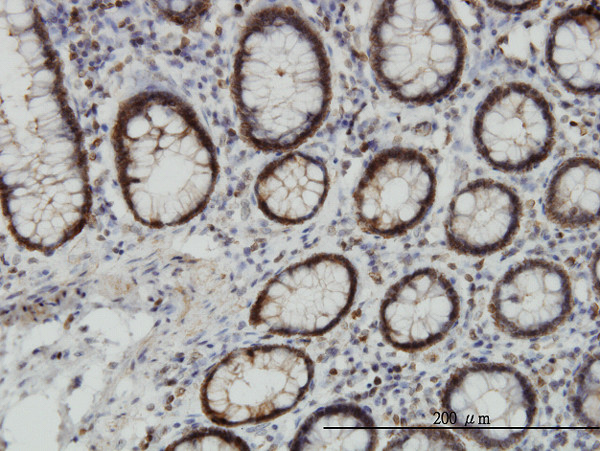
EPHB3 Antibody in Immunohistochemistry (Paraffin) (IHC (P))

Search
Abnova
EPHB3 Monoclonal Antibody (2G8)
{{$productOrderCtrl.translations['antibody.pdp.commerceCard.promotion.promotions']}}
{{$productOrderCtrl.translations['antibody.pdp.commerceCard.promotion.viewpromo']}}
{{$productOrderCtrl.translations['antibody.pdp.commerceCard.promotion.promocode']}}: {{promo.promoCode}} {{promo.promoTitle}} {{promo.promoDescription}}. {{$productOrderCtrl.translations['antibody.pdp.commerceCard.promotion.learnmore']}}
产品信息
H00002049-M04
宿主/亚型
分类
类型
克隆号
抗原
偶联物
形式
浓度
规格
保存条件
运输条件
产品详细信息
Sequence of this protein is as follows: AASLKVIASA QSGMSQPLLD RTVPDYTTFT TVGDWLDAIK MGRYKESFVS AGFASFDLVA QMTAEDLLRI GVTLAGHQKK ILSSIQDMRL QMNQTLPVQ
靶标信息
EPHB3 is a receptor tyrosine kinase that belongs to the ephrin receptor family. Members of the Eph family of kinases play important roles in diverse biological processes including nervous system development, angiogenesis and neural synapsis formation and maturation. The ephrin ligands and Eph receptors display reciprocal expression in vivo. Developing and adult neural tissue express nearly all of the Eph receptors and ephrin ligands. Ephs and ephrins play a significant role in angiogenesis.
仅用于科研。不用于诊断过程。未经明确授权不得转售。